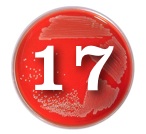
day17
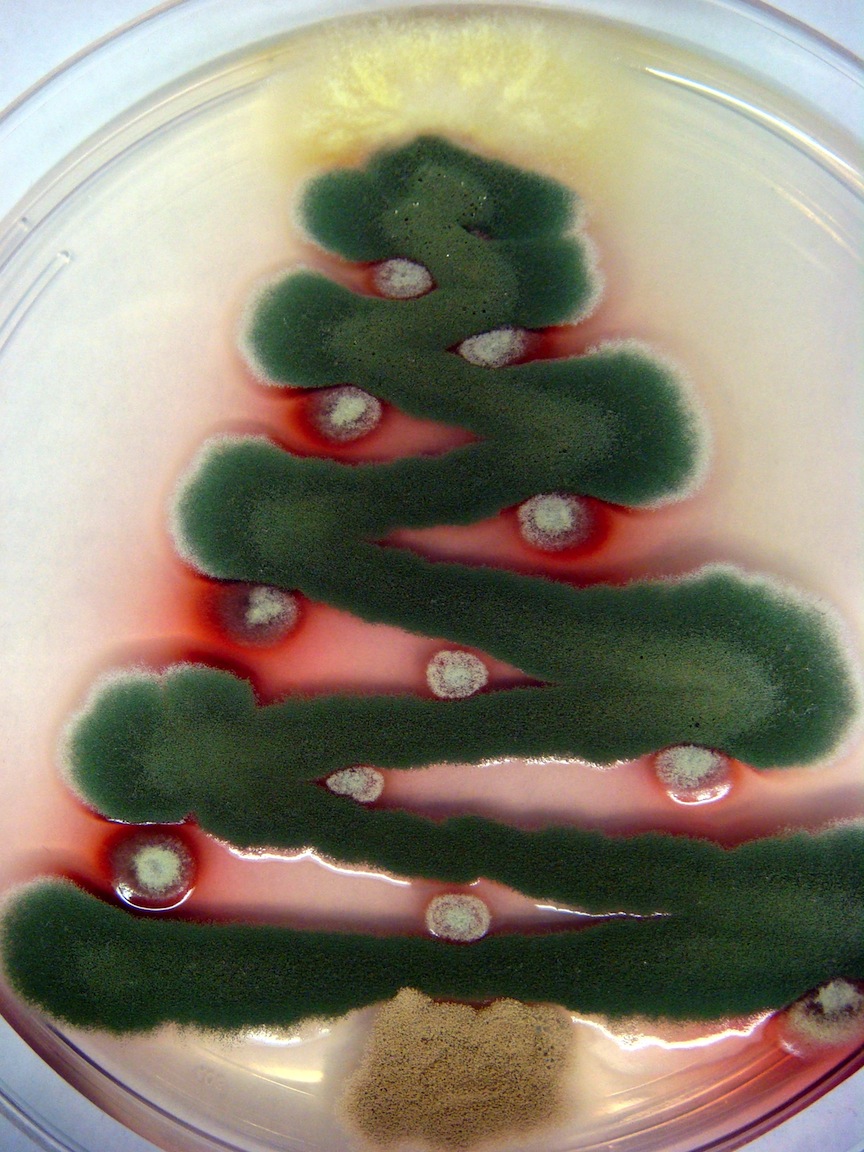
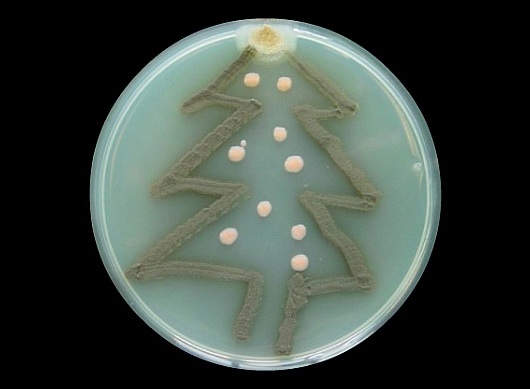

GEEKY LABORATORY CHRISTMAS PLAYS
Collected works by Vince Li-Cata
– – –
IT’S A DEBATABLE CHRISTMAS
Hello, Hello Everyone, and welcome to the Special Christmas Edition of The Sean Connery Show. I’m your host. You know, of course, me as the star of Zardoz and Dragonheart, but my friends just call me Sir Sean Connery. Thank you, thank you – please hold your applause.
On today’s Special Christmas Edition of The Sean Connery Show we have a real treat for you Yanks…it’s the First Ever U.S. Public Debate Among Candidates for the Next Director of the National Institutes of Health. Please hold your applause.
Now many of you might be thinking: Hey, wait a minute Sean, the NIH Director is an appointed position, not an elected one. But that’s what makes our field of candidates so special: these driven and committed men and women don’t let little facts like this get in their way, no, they drive around them – and that’s what makes America the great nation that it is – and that’s why I love America. Now, without any further ado, let’s meet your candidates for the next Director of the NIH.
– – –
EPISODE 5.5: A JEDI WINTER SESSION
Leia: Governor, I thought it was you, I recognized your stench.
Darth Governor: It is a pleasure to see you again, too, Professor Leia. You’re looking particularly fetching today. Perhaps you’d care to join me for a drink after I finish destroying the Foreign Languages programs.
Leia: In your dreams, Governor.
Darth Governor: Perhaps a candy cane, then? (he holds out a candy cane). Oh, I forgot your hands are tied! Too bad, maybe next time.
Leia: Release me Governor. You have no conflict with the Biological Sciences department.
Darth Governor: On the contrary, Professor Leia, you and your colleagues continue to annoy me with your incessant support for the theory of evolution.
– – –
HOW THE PINCH STOLE CHRISTMAS!
NARRATOR: Every Who
Down in U-ville
Liked their research a lot…
But the Pinch
Who lived just North of U-ville
Most certainly, did not.
The Pinch hated Research, the whole Academic season
Now please don’t ask why. No one quite knows the reason.
It could have been the investment firms
Or maybe the banks
Perhaps the subprime loan terms
That made fools of Goldman Sachs,
But whatever the reason, or perhaps due to them all,
The result was his budget was two sizes too small.
– – –
LITTLE ASSISTANT PROFESSOR ANNIE
Dr. Farrell: I used to sing a song in lab. A very special song. To cheer me up. I think have a copy of it with me. (She reaches in her pocket and pulls out a piece of paper and gives it to Annie). I had it published in the Journal of Biological Kinetics. You can use it whenever you feel sad or blue, just don’t forget to reference it properly. Why don’t you go ahead and try it now?
Annie: Should I?
Dr. Farrell: Sure, Annie, sure. Sing the bloody song, I could use the citations.
Annie: (sings, with music)
I’m gonna get grants
Tomorrow
Bet your bottom dollar
That Tomorrow
There’ll be funds…
– – –
MIRACLE ON THE 34TH REPLICATE
(She sings to the tune of “It’s beginning to look a lot like Christmas)
It WAS …. beginning to look eukaryotic!
Instead of slimy goo.
The bacteria soon will grow, into a Jane or Joe
And all my Christmas dreams will soon come true.
It’s beginning to look eukaryotic!
Mutant DNA.
But the prettiest sight to see, is the human that she’ll be
At the end of the day.
– – –
IT’S A WONDERFUL LAB
GEORGINA: (enters her lab, there is no one there) Hello? Hello? Is there anybody here? Well, isn’t this a wonderful lab? Where is everybody? (shouting) Hello? Hello? (she walks around) Look at this, a bunsen burner just left on, spewing gas without a flame! (She turns off the bunsen burner) And the pH probe just hanging in the air, drying out! (She puts away the pH probe). Hello? If you’re not going to be here could you all at least turn off the bunsen burner and put away the pH probe?
(Jethro and ZuZu enter. They are Georgina’s graduate students. Jethro is a good ole boy, wears his hat backwards, talks about football most of the time, etc. ZuZu is a child of the cosmos)
– – –
A BIO-CHRISTMAS CAROL
PAST: I have taken the form of a Developmental Biologist, so as not to frighten you. I have come to show you your Past, Dr. Scrooge. (Explaining) You know, to show you your “Development”. Get it?
SCROOGE: Get out of my house before I call the police.
– – –
(Sorry for being a day late with this advent calendar addition. see more of Popperfont’s Sciencegeek Advent Calendar Extravanganza here)